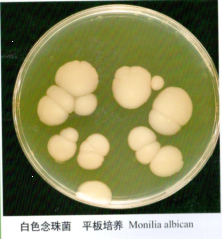
w1.jpg

|
|
分享有趣的商品归类和关务知识,关注尹主任,做好关务人。
4 t# V% T* [1 n$ [
! A, Y0 l# B9 ], O2 _$ E 根据《中华人民共和国国境卫生检疫法实施细则》及《出入境特殊物品卫生检疫管理规定》,进出境特殊物品必须向海关申报,接受海关卫生检疫监督管理。未经海关许可,不准入境、出境。
) b% j/ _: A( f ^8 c& _" e7 F9 n/ f R# t
015 e6 b% N/ S h- K+ w% A: r
+ @$ q8 P" P& W+ a8 u8 o7 I4 P什么是特殊物品?
. m" F8 m, r: }+ e; o3 h# n
8 X0 h: W5 C) w8 S
 : B" U* \2 l' {% ~4 b8 c- O& W
: B" U* \2 l' {% ~4 b8 c- O& W
8 ], ]( N& G2 ?2 l) L
7 I( A9 o6 c* h5 t- D
7 I( A9 o6 c* h5 t- D
: ]8 @3 d0 [% m( u8 W( t 7 ]9 J$ d* V8 E4 F) \5 W 7 ]9 J$ d* V8 E4 F) \5 W
* \( g7 g4 x9 i

% h* Y4 N# d- g. C
8 P* a a4 {: ?: U《出入境特殊物品卫生检疫管理规定》(原质检总局令第160号,海关总署第243号令修改)明确了微生物、人体组织、血液及其制品和生物制品等特殊物品的定义,具体如下:" E9 t2 I: e, J& z3 `* g
6 o; H; M* N( e1- {/ N; l) v1 m# \
( {! c4 ^9 i9 I% u1 A5 }3 d微生物
) B' E* \" Y2 U8 j" h0 y$ y2 c
" O, G$ _" @5 X2 j2 b; e- G3 E6 J是指病毒、细菌、真菌、放线菌、立克次氏体、螺旋体、衣原体、支原体等医学微生物菌(毒)种及样本以及寄生虫、环保微生物菌剂。 y. X/ c, r5 T7 Y0 b
) A' P: E3 ?# H+ L/ _; G20 @. w# N2 H" D6 |
& s4 G. A, Y: i( t, E人体组织. n8 R& Z- e+ P* e
2 k8 j+ V& T G/ j, p
是指人体细胞、细胞系、胚胎、器官、组织、骨髓、分泌物、排泄物等。
* U) H& ]' o1 ^& L4 y& j
- H' o2 |* a8 i2 Y: e! N$ [3
" ?1 R! ]1 N- v4 w" R' v- M
: n z5 s4 B6 d$ G生物制品0 y2 S; o8 q) x# ~# {7 o
/ D& }( z9 C0 A7 `& b
是指用于人类医学、生命科学相关领域的疫苗、抗毒素、诊断用试剂、细胞因子、酶及其制剂以及毒素、抗原、变态反应原、抗体、抗原-抗体复合物、核酸、免疫调节剂、微生态制剂等生物活性制剂。7 a% x6 O# J: e' [/ {3 `4 E+ G
3 T( u4 H: f9 N% o4: E: _ L5 w3 C2 g' S) @- g
0 p* ]1 A. O9 m& H. B" P. `血液及其制品4 p! ^8 `, ?# Z' ~2 n& i/ q) J, ]
" J, K% D/ S6 H/ _0 H) n
血液是指人类的全血、血浆成份和特殊血液成分。血液制品是指各种人类血浆蛋白制品。
! c! M! j* s1 }1 p- X& o8 R* \/ H
! F! y% K6 s/ `; Y02
$ y: ^) g2 I% ~4 ?3 M- ? Z: p5 n8 {8 n8 y1 s
特殊物品的管理制度有哪些?6 Z8 K& E: H2 W" ]) d8 v
: v( o7 ?! v/ d# |/ y- `
出入境特殊物品实行风险分级管理,按照风险程度高低分为A、B、C、D四级,A、B级为高风险特殊物品,C、D级为低风险特殊物品。根据风险等级不同,分别采取检疫监管措施。
2 `! m" H1 J: t& U7 W* v' s6 W: q8 P# [2 w) X
03$ J5 m3 {! K* [3 `$ p* |
: g. d6 P- M% B( _
不同等级的特殊物品包括哪些?8 i. e; ^4 U: u* F4 {7 H1 b( q* i
2 {* J% i6 v, R
A级包括:
; U- s5 O" q) |0 o, f3 D/ ~, {" K( Y9 h6 D C! n
●含有《人间传染的病原微生物名录》中的一、二类病原微生物的特殊物品;
1 }- g8 p- y: g5 j5 D) h; ?
. M+ M" w/ V. s3 P& o' j. o; e●入境的人体血液、血浆、组织、器官、细胞、骨髓;
3 @# D3 L, L/ `0 S/ g- W$ y8 u+ `3 e- T. u: T
●涉及人类遗传资源的出境特殊物品;
* {9 ^! D2 }' U0 K* F! r. O" z! w% a
●环保微生物菌剂。
7 T+ W( y0 E; }/ q) N F; e
6 Y1 X& r) I% X7 k! H+ r, sB级包括:) W" `. r6 X/ W( h; ?
% s9 U$ O7 I1 j$ V●含有《人间传染的病原微生物名录》中的三类病原微生物的特殊物品;1 C4 Y. b; e) Z ]7 Z& w( a
9 [8 E4 o: @+ ^# `●可能含有一、二、三类病原微生物及尚未认知其传染性的特殊物品;' g+ C; o9 Z0 M% B6 `
m% F% F$ U( m, Q" D+ {●含有或可能含有寄生虫的特殊物品;# s# U2 L8 d9 D, v5 D& s2 a4 ]$ T0 j
i1 r6 M' K% u# m' N7 X●一、二类病原微生物完整或修饰基因组核酸物质;+ [" l* S& X Y6 h8 a4 o% n! H+ {
' F# A+ {) u* A0 w9 u●由病原微生物产生的,以及已知对人类有害的毒素;1 t( B" s0 Z+ A
+ }! ?" J* S7 ~8 B
●未经裂解或纯化工艺不完全的蛋白类产品。& N3 _! {1 a4 ~$ q! q* [0 q. Z
2 M3 B# t5 P! l S5 l; Y& e1 U
C级包括:: J- ~) x8 n( w3 H6 q
c/ j6 Y3 R; Q●含有《人间传染的病原微生物名录》中四类病原微生物及名录以外的其它医学微生物;
% _/ B3 n0 k1 Z2 }1 M
! ]: J% A$ P, t9 `: |9 d9 i* f2 [●国际知名菌种保藏机构(如ATCC、CMCC)商品化科研用(非临床用)细胞株(系);' b4 R- U3 _& @) |
) L5 |3 ]& \$ Q1 d, ^7 c
●经裂解或纯化的蛋白类产品,如酶、抗体、细胞因子、激素、重组蛋白、多肽等(毒素和朊病毒除外);' I- s% F F# l7 ^0 X8 v) r) v5 F$ ]
5 }9 o; h9 b& _/ o: E: w9 ]●除一、二类病原微生物完整或修饰基因组核酸物质以外的核酸物质,如文库(基因组文库、互补DNA文库、噬菌体展示肽文库等)、引物、质粒DNA、RNA等;
3 J( v& O: y; k- H5 g9 E$ B5 X. L1 ?$ j! A8 z
●用于与人类疾病预防、诊断、治疗活动有关的注册、临床试验目的特殊物品;$ z/ a* Y- L5 ~6 F4 H
6 b$ c# T* |( Q4 P% W2 ^/ l●一般情况下不会引起人类疾病的其他特殊物品。 m2 ?1 A% K: c6 M
' d8 t+ f6 p& V& w3 P9 ~3 ]4 h
D级包括:
1 e2 `- W( ^1 F* S P8 i4 z: C0 N
●已获得药品注册证/出口销售证明的入/出境人用疫苗或其他预防用生物制品;
2 u( \" G% L, Q, |6 o6 r# m: C1 l5 ?$ n! N5 B* l" r8 w
●已获得医疗器械注册证/出口销售证明的入/出境体外诊断试剂;5 s$ f3 e1 {. X7 o
& M8 t- b! C, I% }! U2 A
●已获得药品注册证/出口销售证明的入/出境治疗用生物制品/血液制品。
/ F. e, z2 V0 W. F! L3 l
8 A: u: D, n5 W q& X5 h04
. i. O8 r- g# n( {
" [. S$ v; I+ k3 a% Z g' c哪些级别的特殊物品
7 i& v+ B2 E3 w# x) M9 \2 r
# Q" H& T; {9 Z3 D# |需要经过风险评估?
' T2 N" m8 r* m
. A# w5 a: c+ X0 s5 x对于无法获得国家主管部门批文的A级特殊物品和所有的B级特殊物品,需要海关组织风险评估,通过风险评估后,才可以申请审批,A级特殊物品审批单有效期是3个月,不可以分批核销,B级特殊物品审批单有效期是6个月,可以分批核销。
3 I: ~3 B t/ v- L6 T. ?1 v# _( D, c& }& R. H0 L
A、B级特殊物品进口后,还需要向当地海关申请后续监管,在后续监管合格后才可以使用。2 ]6 G+ h' ^5 m1 E9 \5 A; H7 `: j
; A d% i0 j4 q i6 n5 X05
, c* ~) A& @. V; x
2 f: X' c& k/ D. }风险评估有哪些形式?
' J1 Y+ ~6 I2 l% W, I4 F U# K
& x0 a+ n* S( W# @3 m6 n风险评估一般分为线上、网络视频会和现场会三种形式。
* A$ X( H8 g7 m& [# M6 H) \" }5 e. q8 \4 A( j4 \! d
线上评估是企业通过H2018-海关特殊物品出入境卫生检疫审批与分析系统直接提交,20个工作日内会得到相应的风评报告。# |. P, e: H t6 z6 w0 J
6 e' y1 F* `2 j# v9 b) d" r6 Z; T网络视频会和现场会由海关组织,企业需要在网络视频会议和现场会上汇报产品信息和企业生物安全控制能力等相关内容的ppt,并回答专家提问2 c; H6 Y$ m* ^0 ]: U
3 @7 z7 z1 S2 A" g! Y8 f9 E / ?: p/ m9 A! J1 l @$ X / ?: p/ m9 A! J1 l @$ X
. X1 a1 K1 i+ ^4 E* L5 Z* @
06
! G' b; n, {3 v) W
7 l1 n8 o1 M# K5 K0 p: @风险评估申请流程?& Q8 F8 ]* I+ b2 g
( ^8 x$ K3 C( e6 z
线上流程是企业在H2018-海关特殊物品出入境卫生检疫审批与分析系统上提交A、B级特殊物品风险评估的申请,并通过电话或者企业微信群等方式,告知审批人员申请单流水号。
$ @ n' l/ L% N% G
& u, v) I) H4 o' Q: Y- ]* h: |7 g如以网络视频会和现场会形式参加风险评估,必须至少提前三天提交风险评估申请材料。& e2 f$ I/ T+ } V `
/ n* U" i1 ~: z, y1 h) [077 V2 n( ?( l0 r
1 v) S8 j6 f( {风险评估需要提交哪些材料?* a8 g- C% O3 A5 e, x
4 U% [6 W+ h' P1 l015 ~) J1 A8 N4 ^0 z2 z4 Q( h- k
. |& x+ X, ~4 X e8 D特殊物品单位相关情况(说明性材料,营业执照等);
5 w e. _; d8 a' ^0 V
+ l4 P$ J3 Q/ D4 @3 v5 g6 h02: M( y7 U4 ^* S; n; Q$ ]
1 X z' K# A$ H' o生物安全控制能力相关文件及记录(生物安全实验室备案证书,生物安全控制体系及操作规范,相关培训演练记录和影像材料,生物安全关键设备计量证书等材料);9 H; E1 _, U2 a1 C' G
5 D- d+ N! U# \0 t6 Q- `- q6 ~% I( D03
% H/ P" L- [1 t- Y1 L) e
8 b+ ?8 O- D) }2 S3 s* h6 c0 k特殊物品相关材料(说明性材料,来源(人源物品需提交采集方是否通过伦理审查的材料,官方批文(如国内外临床试验的官方批准文件等))、用途(课题立项文件、研发外包协议等)、制备工艺或使用流程、病原微生物排除措施、国外官方证书/检测报告、产品说明书、COA等);
+ V4 z3 U, |0 U- J
: I( z2 J9 g+ N( J04% d5 d( q1 c/ M1 @' {% c% o
. J1 h6 \. y' o; x D被委托承运方资质及工作人员上岗资质证书;3 j* o+ ?; `% X+ V/ m) U/ i
" |! s, F" u" a: S9 J* G' x! T& a
05& e$ R* F }. B) z2 J
- \- r5 D {' O" U
运输、包装相关协议、文件、资质等材料、计划等;
, |; N3 t( z" {/ s9 O+ x3 {
7 {7 V! m4 v9 L# }, e06, Z, T: d! k8 k+ M. `0 A
7 C& q2 b1 [1 \0 G
医疗废弃物处置合同(包括承担处置废弃物机构的资质证书和运输废弃物机构的资质证书)。
- _6 l7 \) U i& ?) F
w' m( A6 g3 N% C- H: \08
\( B" `1 @7 i9 n3 ^' A. C2 C1 w3 w& K
风险评估后如何申请审批单?
% N m$ D% I: o- l1 M
# d }2 h5 e) m. l- }* y9 @' U" e第一步
! R6 o. s4 w7 b/ }/ U/ k/ R. ^2 [4 Z2 h$ M! N5 f+ O' h% u, b
参评企业严格按照文审报告中专家意见,补充相关材料。补正材料放在一个文件里,第一页为补正说明,列明专家给出的补正意见,针对补正意见给出补正结果,并附上佐证材料,最后附上文审报告,材料较多的可以建目录。文件名命名规则企业名称+产品名称+风评补正。. G0 A# E, l2 j0 Y! J' m' ^% h
, K* i* h" b8 I' t: u; r8 Z6 t
第二步
/ l a s" y( }3 a! h' K* T, D& S2 N3 v, l
补正材料经过专家组审核后,审批人员将邮件转发给对应的参评单位。如果专家组评估补正已经通过,则企业在H2018-海关特殊物品出入境卫生检疫审批与分析系统提交风险评估申请,海关会出具风险评估报告。
; N! Z# D/ s8 c9 P8 X( U) }% j8 t' t* Z- E! D% p: P1 C
第三步
# [4 m2 o4 H. }& o# `& ?" W! F, r. }& _3 N' B8 R: P; f
参评企业凭风险评估报告申请特殊物品卫生检疫审批单,参评企业将该补正材料专家审核通过的邮件截图,和风险评估报告以及相关申请材料提交审批申请,海关按要求开展特殊物品卫生检疫审批。
2 k, r [4 P' _ }' S. f0 R; J0 d3 D! s% H1 F
·END·$ ?4 J$ x+ u* B+ v4 f
5 l8 N* w2 [- a4 D2 i( p( m Q0 W
8 ~) L2 i- p6 e2 m1 d编辑 | 尹主任
+ j" k/ @' g3 s专注于关务合规、商品归类、AEO认证' v" D+ n! d2 }: \* r
% ~5 X4 V% L9 _- p' d P
手机及微信 | 13789072282 % {# c$ M: [4 w! K
( A. w- |4 P4 N) k/ l, ?
- h( U8 A! a6 u
免责声明▼ 本微信公众号所发表内容,凡注明来源的,其版权均归属于原出处所有(未注明版权或者无法查证版权的,归属于网络搜集整理)。转载内容(音视频、文字内容等)只以分享关务合规及商品归类及信息传播为目的,仅供参考,不代表本平台认同其观点及立场,其内容的真实性、准确性及合法性,由阅读者各位自行判断、自行负责。任何依照本公众号内容去指导自身企业运营活动实操的行为都属于企业自身行为,所产生的一切法律后果均与本公众号无关。如认为本公众号内容涉及版权问题,请即刻与本公众号联系或后台留言,我们将第一时间核实后做删除处理
6 E: w! D) s2 c+ j* t( @3 } z- W+ z {
8 R8 l) R8 b3 W2 j& V B$ ~
2 C9 t4 K1 Y: A) x% D
/ n/ w+ P" f+ c- m2 p7 w以上内容仅供参考,具体办理流程咨询属地海关。; g& O- Y! ?# r& {7 l# u" B5 n
9 r0 Q! A+ U- C( w: W% m k6 J
文章综合整理自苏州工业园海关 |
|

 /2
/2 
 |Archiver|手机版|小黑屋|外贸精英网
( 京ICP备19046145号 )
|Archiver|手机版|小黑屋|外贸精英网
( 京ICP备19046145号 )